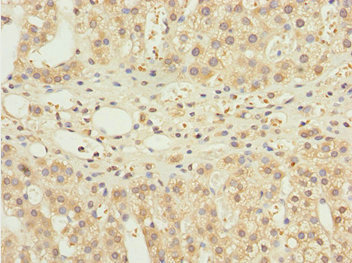

NBR1 Antibody
-
中文名稱:NBR1兔多克隆抗體
-
貨號:CSB-PA622775ESR1HU
-
規(guī)格:¥440
-
圖片:
-
其他:
產(chǎn)品詳情
-
產(chǎn)品名稱:Rabbit anti-Homo sapiens (Human) NBR1 Polyclonal antibody
-
Uniprot No.:
-
基因名:
-
別名:1A1 3B antibody; 1A13B antibody; B box protein antibody; Cell migration-inducing gene 19 protein antibody; KIAA0049 antibody; M17S2 antibody; Membrane component chromosome 17 surface marker 2 antibody; Membrane component, chromosome 17, surface marker 2 (ovarian carcinoma antigen CA125) antibody; MIG 19 antibody; MIG19 antibody; Migration inducing protein 19 antibody; NBR 1 antibody; Nbr1 antibody; NBR1, autophagy cargo receptor antibody; NBR1_HUMAN antibody; Neighbor of BRCA1 gene 1 antibody; Neighbor of BRCA1 gene 1 protein antibody; Next to BRCA1 gene 1 protein antibody; Ovarian carcinoma antigen CA125 antibody; Protein 1A1-3B antibody
-
宿主:Rabbit
-
反應(yīng)種屬:Human
-
免疫原:Recombinant Human Next to BRCA1 gene 1 protein (1-280AA)
-
免疫原種屬:Homo sapiens (Human)
-
標(biāo)記方式:Non-conjugated
-
克隆類型:Polyclonal
-
抗體亞型:IgG
-
純化方式:Antigen Affinity Purified
-
濃度:It differs from different batches. Please contact us to confirm it.
-
保存緩沖液:PBS with 0.02% sodium azide, 50% glycerol, pH7.3.
-
產(chǎn)品提供形式:Liquid
-
應(yīng)用范圍:ELISA, IHC
-
推薦稀釋比:
Application Recommended Dilution IHC 1:20-1:200 -
Protocols:
-
儲存條件:Upon receipt, store at -20°C or -80°C. Avoid repeated freeze.
-
貨期:Basically, we can dispatch the products out in 1-3 working days after receiving your orders. Delivery time maybe differs from different purchasing way or location, please kindly consult your local distributors for specific delivery time.
-
用途:For Research Use Only. Not for use in diagnostic or therapeutic procedures.
相關(guān)產(chǎn)品
靶點(diǎn)詳情
-
功能:Acts probably as a receptor for selective autophagosomal degradation of ubiquitinated targets.
-
基因功能參考文獻(xiàn):
- NBR1 is not required for PARK2-dependent mitophagy. PMID: 26512954
- The NBR1 depletion impairs FA turnover and decreases targeting of autophagosomes to FAs, whereas ectopic expression of autophagy-competent, but not autophagy-defective, NBR1 enhances FA disassembly and reduces FA lifetime during migration. PMID: 26903539
- NBR1 positively correlates with adipose inflammation in human obese patients. PMID: 25043814
- Analysis of muscle biopsies of sporadic inclusion body myositis (sIBM) patients revealed a strong decrease of NBR1 phosphorylation in muscles of sIBM patients that directly correlated with the severity of protein aggregation. PMID: 24879152
- The C-terminal fragments of SQSTM1 and NBR1 exhibited a dominant-negative effect against native SQSTM1/NBR1, probably by competing for LC3 and ubiquitin chain binding. PMID: 24769734
- structure of the ubiquitin-associated (UBA) domain of human autophagy receptor NBR1 and its interaction with ubiquitin and polyubiquitin PMID: 24692539
- results suggest that NBR1 is the specific autophagy receptor for pexophagy. PMID: 23239026
- These findings suggest that NBR1 is involved in the formation of cytoplasmic inclusions in alpha-synucleinopathy. PMID: 22484440
- The structural ensemble representing each of the two sequential folding transition transition states of the PB1 domain of NBR1 has been calculated using experimental Phi values and biased molecular dynamics simulations. PMID: 21121670
- Autophagy-related NBR1 protein is not involved in the formation/degradation of neuronal intranuclear inclusions in neurodegenerative diseases. PMID: 22728060
- Breast and ovarian cancer risk are high in Jewish women with BRCA1 genetic mutation. PMID: 22430266
- AtNBR1 is more similar to mammalian NBR1 than to p62 in domain architecture and amino acid sequence. PMID: 21606687
- Results indicate that the presence of a tryptophan residue in the LIR motif increases the binding affinity of GABARAPL-1/NBR1-LIR complex. PMID: 21620860
- interacts with two proteins; fasciculation and elongation protein zeta-1 (FEZ1), a PKCzeta interacting protein, and calcium and integrin binding protein (CIB), also shows developmentally restricted expression in the neural tube PMID: 11856312
- NBR1 together with p62 promotes autophagic degradation of ubiquitinated targets and simultaneously regulates their aggregation when autophagy becomes limited. PMID: 19398892
- The nbr1 UBA domain binds to lysine-48 and -63 linked polyubiquitin-B chains. Nbr1 also binds to the autophagic effector protein LC3-A via a novel binding site. PMID: 19427866
- findings suggest a critical function for NBR1 in the regulation of receptor trafficking and provide a mechanism for down-regulation of signaling by Spred2 via NBR1. PMID: 19822672
顯示更多
收起更多
-
亞細(xì)胞定位:Cytoplasm. Cytoplasmic vesicle, autophagosome. Lysosome. Cytoplasm, myofibril, sarcomere, M line.
-
數(shù)據(jù)庫鏈接:
Most popular with customers
-
-
YWHAB Recombinant Monoclonal Antibody
Applications: ELISA, WB, IHC, IF, FC
Species Reactivity: Human, Mouse, Rat
-
Phospho-YAP1 (S127) Recombinant Monoclonal Antibody
Applications: ELISA, WB, IHC
Species Reactivity: Human
-
-
-
-
-